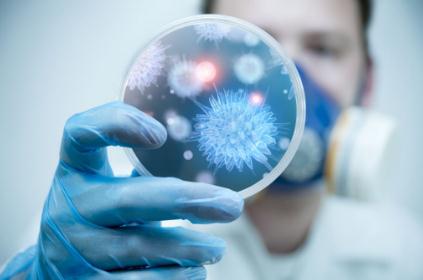
病毒

隨著氣溫逐漸下降,輪狀病毒、諾如病毒等感染性腹瀉疾病進入高發季節。中國疾控中心提醒,每年10月到次年3月是諾如病毒感染的高發期,這種病毒具有感染劑量低、排毒時間長、外環境抵抗力強等特點,是引起急性胃腸炎常見的病原體之一。感染后主要表現為胃腸道癥狀,如惡心、嘔吐、發熱、腹痛、腹瀉,兒童以嘔吐為主,成人則以腹瀉居多。專家強調,預防是關鍵,公眾應做好個人防護,出現癥狀及時就醫。
一、兩種病毒的主要區別與特點
1. 感染人群差異:輪狀病毒主要感染嬰幼兒,尤其是6個月至24個月的嬰兒,超過4歲后感染概率明顯降低。而諾如病毒全年齡段均可感染,成人及學齡兒童暴發更常見,養老院、學校等集體單位易發生聚集性疫情。
2. 癥狀表現不同:輪狀病毒感染初期常見發熱和嘔吐,隨后出現蛋花湯樣水便,每日可達10-20次,易導致脫水。諾如病毒以突發劇烈嘔吐為主,成人腹瀉多為稀水便,兒童可能嘔吐腹瀉并存,癥狀通常持續1-3天。
3. 傳播途徑多樣:輪狀病毒主要通過糞-口途徑傳播,接觸被污染的玩具、衣物等可間接感染。諾如病毒除糞-口傳播外,嘔吐物產生的氣溶膠可經空氣傳播,密閉空間內傳播力極強,少量病毒顆粒即可致病。
二、科學有效的預防措施
1. 保持良好個人衛生:飯前便后要按照六步洗手法正確洗手,用肥皂和流動水至少洗20秒。需要注意的是,含酒精消毒紙巾和免洗手消毒劑對諾如病毒無效,不能代替洗手。在接觸公共物品后、準備食物前都要清潔雙手。
2. 注意飲食飲水安全:不飲用生水,蔬菜瓜果要洗凈,烹飪食物要煮熟,特別是牡蠣和其他貝類海鮮類食品更要煮熟煮透后食用。避免食用生冷食物,不食不潔、無證食品。
3. 做好環境清潔消毒:保持室內良好的空氣流通,每日開窗通風不少于2次,每次不少于30分鐘。對患者嘔吐物或糞便污染的環境和物品需要使用含氯制劑進行消毒,在清理污染物時要做好個人防護,避免直接接觸。
三、感染后的正確處理方法
1. 及時補液防止脫水:感染后最關鍵的是防止脫水,輕度脫水可通過口服補液鹽緩解,嚴重脫水者應接受靜脈補液治療。可以準備一些口服補液鹽,或者掌握如何配置鹽米湯的方法,在500毫升的米湯里加入1.75克的食鹽,讓孩子少量多餐地喝。
2. 合理飲食調理:急性腹瀉期間一般無需禁食,補液治療4小時內應恢復飲食,少食多餐,進食少油、易消化及富含維生素和微量元素的食物,如米湯、蜂蜜水、藕粉、蘇打餅干、酸奶等。避免食用油膩、辛辣、高纖維食物。
3. 正確用藥治療:目前沒有抗病毒藥物,主要采用對癥支持治療。腹瀉嚴重時可遵醫囑使用蒙脫石散等止瀉藥物,伴有腸道菌群失調時可使用益生菌制劑。需要注意的是,病毒感染性腹瀉不應濫用抗生素,否則可能導致腸道菌群失調,加重腹瀉。
結語
輪狀病毒和諾如病毒作為秋冬季常見的腸道病毒,雖然癥狀相似但各有特點。預防的關鍵在于保持良好的個人衛生習慣、注意飲食飲水安全、做好環境清潔消毒。一旦感染,要及時補液防止脫水,合理飲食調理,并在醫生指導下進行對癥治療。通過科學有效的預防和治療措施,可以有效降低感染風險,保護個人和家庭健康。(來源:39健康)








